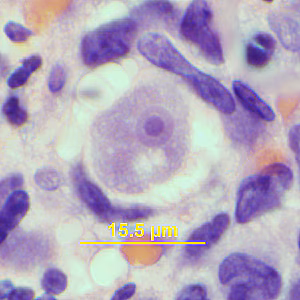
Case341_C.jpg

Case #341 – February, 2013
A 58-year-old man sought medical attention for numerous nodules on the right upper arm and forearm. He had recently relapsed with lymphocytic leukemia. Two weeks prior to the presentation of the nodules he was diagnosed with pneumonia and was also being treated for Clostridium difficile colitis. Skin biopsies of the nodules were collected and sent to Pathology for routine sectioning and staining. Numerous cells resembling histiocytes were observed and were noted on Periodic acid-Schif stain (PAS) as positive and on Gomori-Grocott methenamine silver stain (GMS) as negative. However, the GMS-stained sections revealed possible cysts. Images were captured by the attending pathologist and sent to DPDx for diagnostic assistance. Figure A shows one of the cysts observed on a GMS-stained section. Figures B and C show organisms observed on hematoxylin-and-eosin (H&E) stained sections. Figure D shows an organism on a PAS-stained section. All images presented were captured at 1000x magnification. Embedded measurements were provided by the submitter. What is your diagnosis? Based on what criteria?

Figure A

Figure B
Figure C

Figure D
This case and images were kindly provided by Emory University School of Medicine, Atlanta, GA.
Images presented in the DPDx case studies are from specimens submitted for diagnosis or archiving. On rare occasions, clinical histories given may be partly fictitious.
DPDx is an educational resource designed for health professionals and laboratory scientists. For an overview including prevention, control, and treatment visit www.cdc.gov/parasites/.
